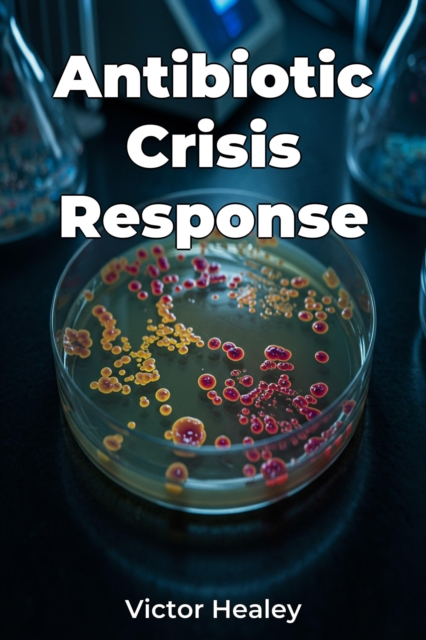
Antibiotic Crisis Response

Antibiotic Crisis Response
"Antibiotic Crisis Response" addresses the escalating global threat of antibiotic resistance, examining its biology, socio-economic drivers, and potential solutions. The book highlights how common infections may become untreatable, emphasizing the critical need for coordinated efforts from governments, researchers, and public health organizations.
Did you know that antibiotic overuse in agriculture...
"Antibiotic Crisis Response" addresses the escalating global threat of antibiotic resistance, examining its biology, socio-economic drivers, and potential solutions. The book highlights how common infections may become untreatable, emphasizing the critical need for coordinated efforts from governments, researchers, and public health organizations.
Did you know that antibiotic overuse in agriculture...
